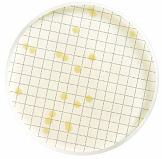

Поиск по сайту
Фраза для поиска:





























Бульон с индикатором ТТС
HPC с индикатором TTC, HPC Broth with TTC Indicator, общее микробное число (Total Bacteria), пластик 2 мл (50 шт. в уп.)
Бульон используется в пищевой, фармацевтической и микроэлектронной промышленности для контроля качества конечных продуктов, жидкостей и технологических вод, используемых при производстве этих продуктов, для выявления потенциальных организмов порчи. Среда предназначается для подсчета ОМЧ при температуре инкубации 35°С. На этой среде, содержащей индикатор, способны расти любые микроорганизмы. Колонии окрашиваются в красный цвет в результате осаждения формазана, который образуется при восстановлении соли 2,3,5-трифенилтетрозолин-хлорида в результате метаболизма микроорганизмов.